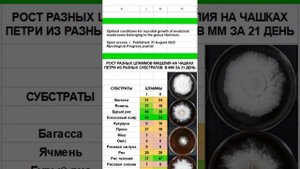
2. выбор зерна для мицелия ежовика гребенчатого.

1:31
1:31
2024-04-20 04:25

 26:01
26:01

 26:01
26:01
2024-09-26 19:17

 1:09:36
1:09:36

 1:09:36
1:09:36
2024-09-25 17:56

 29:05
29:05

 29:05
29:05
2024-09-26 12:57

 6:59
6:59

 6:59
6:59
2023-11-25 16:22

 39:25
39:25

 39:25
39:25
2024-09-27 15:00

 5:22
5:22

 5:22
5:22
2023-11-25 12:50

 20:16
20:16

 20:16
20:16
2025-02-26 23:43

 5:12
5:12

 5:12
5:12
2023-11-25 16:40

 2:19
2:19

 2:19
2:19
2023-11-13 19:42

 1:11:49
1:11:49

 1:11:49
1:11:49
2024-10-02 21:00

 6:15
6:15

 6:15
6:15
2020-06-20 08:47
![Полный цикл выращивания ежовика гребенчатого в двух частях. Часть №1]() 23:22
23:22
 23:22
23:22
2021-04-09 18:15

 6:09
6:09

 6:09
6:09
2023-07-06 14:38
![Полный цикл выращивания ежовика гребенчатого в двух частях. Часть №2]() 7:44
7:44
 7:44
7:44
2021-04-09 18:17
![Снял ежовик гребенчатый, засушил и запланировал сделать новые блоки по новому.]() 8:53
8:53
 8:53
8:53
2021-04-09 18:21

 5:01
5:01

 5:01
5:01
2023-08-26 17:23

 1:25:42
1:25:42
![Илёс Юнусий - Каранг она якинларим (Премьера клипа 2025)]() 3:36
3:36
![Бобур Ахмад - Куролмаслар (Премьера клипа 2025)]() 3:33
3:33
![Сергей Завьялов - В дороге (Премьера клипа 2025)]() 3:14
3:14
![Alex Lim, Игорь Крутой - Вокзал (Премьера клипа 2025)]() 3:32
3:32
![Надежда Мельянцева - Котёнок, не плачь (Премьера клипа 2025)]() 3:02
3:02
![Зафар Эргашов & Фируз Рузметов - Лабларидан (Премьера клипа 2025)]() 4:13
4:13
![Нодир Иброҳимов - Жоним мени (Премьера клипа 2025)]() 4:01
4:01
![Tural Everest, Baarni - Ушедший покой (Премьера клипа 2025)]() 3:01
3:01
![Ислам Итляшев - Не вспоминай (Премьера клипа 2025)]() 2:52
2:52
![Хабибулло Хамроз - Хуп деб куёринг (Премьера клипа 2025)]() 4:04
4:04
![KhaliF - Где бы не был я (Премьера клипа 2025)]() 2:53
2:53
![Артур Халатов - Девочка моя (Премьера клипа 2025)]() 2:37
2:37
![Джатдай - Забери печаль (Премьера клипа 2025)]() 2:29
2:29
![Искандар Шокалонов - Дустларим (Премьера 2025)]() 4:00
4:00
![Бонухон & Сардорбек Машарипов - Шанс (Премьера клипа 2025)]() 3:28
3:28
![A'Studio – Она не виновата (Премьера клипа 2025)]() 2:13
2:13
![Анжелика Агурбаш - Утро (Премьера клипа 2025)]() 3:33
3:33
![ESCO - За тобой (Премьера клипа 2025)]() 2:13
2:13
![NIKA DUBIK, Winter Spirit - Искры (Премьера клипа 2025)]() 4:27
4:27
![Зара - Танго о двух влюбленных кораблях (Премьера клипа 2025)]() 3:10
3:10
![Супруги Роуз | The Roses (2025)]() 1:45:29
1:45:29
![Хищник | Predator (1987) (Гоблин)]() 1:46:40
1:46:40
![Сколько стоит жизнь? | What Is Life Worth (2020)]() 1:58:51
1:58:51
![Богомол | Samagwi (2025)]() 1:53:29
1:53:29
![Дикари | The Savages (2007)]() 1:54:19
1:54:19
![Мальчишник в Таиланде | Changeland (2019)]() 1:25:47
1:25:47
![Непрощённая | The Unforgivable (2021)]() 1:54:10
1:54:10
![Голый пистолет | The Naked Gun (2025)]() 1:26:24
1:26:24
![Терминатор 2: Судный день | Terminator 2: Judgment Day (1991) (Гоблин)]() 2:36:13
2:36:13
![Фантастическая четвёрка: Первые шаги | The Fantastic Four: First Steps (2025)]() 1:54:40
1:54:40
![Голос любви | Aline (2020)]() 2:05:43
2:05:43
![Тот самый | Him (2025)]() 1:36:20
1:36:20
![Положитесь на Пита | Lean on Pete (2017)]() 2:02:04
2:02:04
![Мужчина у меня в подвале | The Man in My Basement (2025)]() 1:54:48
1:54:48
![Государственный гимн | Americana (2025)]() 1:47:31
1:47:31
![Псы войны | Hounds of War (2024)]() 1:34:38
1:34:38
![Сумерки | Twilight (2008)]() 2:01:55
2:01:55
![Вечеринка только начинается | The Party's Just Beginning (2018)]() 1:31:20
1:31:20
![Чумовая пятница 2 | Freakier Friday (2025)]() 1:50:38
1:50:38
![Баллада о маленьком игроке | Ballad of a Small Player (2025)]() 1:42:60
1:42:60
![Тодли Великолепный!]() 3:15
3:15
![Игрушечный полицейский Сезон 1]() 7:19
7:19
![Минифорс. Сила динозавров]() 12:51
12:51
![Умка]() 7:11
7:11
![Котёнок Шмяк]() 11:04
11:04
![Хвостатые песенки]() 7:00
7:00
![Пластилинки]() 25:31
25:31
![Роботы-пожарные]() 12:31
12:31
![Сборники «Умка»]() 1:20:52
1:20:52
![Новое ПРОСТОКВАШИНО]() 6:30
6:30
![Отряд А. Игрушки-спасатели]() 13:06
13:06
![Крутиксы]() 11:00
11:00
![Школьный автобус Гордон]() 12:34
12:34
![Сборники «Ну, погоди!»]() 1:10:01
1:10:01
![Сборники «Простоквашино»]() 1:05:35
1:05:35
![Псэмми. Пять детей и волшебство Сезон 1]() 12:17
12:17
![Забавные медвежата]() 13:00
13:00
![Мультфильмы военных лет | Специальный проект к 80-летию Победы]() 7:20
7:20
![Корги по имени Моко. Домашние животные]() 1:13
1:13
![Пингвиненок Пороро]() 7:42
7:42

 1:25:42
1:25:42Скачать видео
| 256x144 | ||
| 640x360 | ||
| 1280x720 | ||
| 1920x1080 |
 3:36
3:36
2025-11-02 10:25
 3:33
3:33
2025-11-02 10:17
 3:14
3:14
2025-10-29 10:28
 3:32
3:32
2025-10-31 15:50
 3:02
3:02
2025-10-31 12:43
 4:13
4:13
2025-10-29 10:10
 4:01
4:01
2025-11-02 10:14
 3:01
3:01
2025-10-31 13:49
 2:52
2:52
2025-10-28 10:47
 4:04
4:04
2025-10-28 13:40
 2:53
2:53
2025-10-28 12:16
 2:37
2:37
2025-10-28 10:22
 2:29
2:29
2025-10-24 11:25
 4:00
4:00
2025-11-02 10:12
 3:28
3:28
2025-10-24 11:20
 2:13
2:13
2025-10-31 12:53
2025-11-02 10:06
 2:13
2:13
2025-10-31 12:20
 4:27
4:27
2025-10-31 16:00
 3:10
3:10
2025-10-27 10:52
0/0
 1:45:29
1:45:29
2025-10-23 18:26
 1:46:40
1:46:40
2025-10-07 09:27
 1:58:51
1:58:51
2025-08-27 17:17
 1:53:29
1:53:29
2025-10-01 12:06
 1:54:19
1:54:19
2025-08-27 18:01
 1:25:47
1:25:47
2025-08-27 17:17
 1:54:10
1:54:10
2025-08-27 17:17
 1:26:24
1:26:24
2025-09-03 13:20
 2:36:13
2:36:13
2025-10-07 09:27
 1:54:40
1:54:40
2025-09-24 11:35
 2:05:43
2:05:43
2025-08-27 18:01
 1:36:20
1:36:20
2025-10-09 20:02
 2:02:04
2:02:04
2025-08-27 17:17
 1:54:48
1:54:48
2025-10-01 15:17
 1:47:31
1:47:31
2025-09-17 22:22
 1:34:38
1:34:38
2025-08-28 15:32
 2:01:55
2:01:55
2025-08-28 15:32
 1:31:20
1:31:20
2025-08-27 17:17
 1:50:38
1:50:38
2025-10-16 16:08
 1:42:60
1:42:60
2025-10-31 10:53
0/0
 3:15
3:15
2025-06-10 13:56
2021-09-22 21:03
 12:51
12:51
2024-11-27 16:39
 7:11
7:11
2025-01-13 11:05
 11:04
11:04
2023-05-18 16:41
 7:00
7:00
2025-06-01 11:15
 25:31
25:31
2022-04-01 14:30
2021-09-23 00:12
 1:20:52
1:20:52
2025-09-19 17:54
 6:30
6:30
2018-04-03 10:35
 13:06
13:06
2024-11-28 16:30
 11:00
11:00
2022-07-25 18:59
 12:34
12:34
2024-12-02 14:42
 1:10:01
1:10:01
2025-07-25 20:16
 1:05:35
1:05:35
2025-10-31 17:03
2021-09-22 22:23
 13:00
13:00
2024-12-02 13:15
 7:20
7:20
2025-05-03 12:34
 1:13
1:13
2024-11-29 14:40
 7:42
7:42
2024-12-17 12:21
0/0

